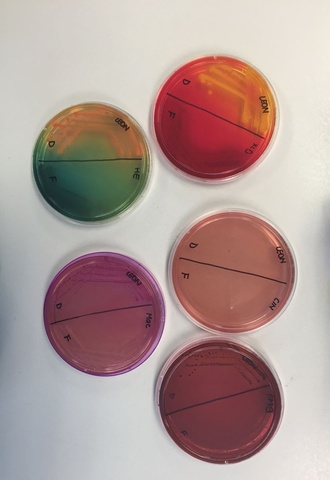
Medios de cultivo

-
En la época de Homero, fue mencionada por primera vez las enfermedades en plantas (Agrios, 2005).
-
Mención de la existencia de plagas que afectaban a los arboles de olivo. Se descubrió que el azufre al ser rociado sobre las plantas, podía controlar dichas plagas (Agrios, 2005).
-
Teofrasto (sucesor de Aristóteles) escribió dos libros: "La Naturaleza de las Plantas" y "Razones del crecimiento de la planta" (Agrios, 2005).
-
Alberto Magno señaló al muérdago como fitopatógeno, debido a que parasitaba ramas de ciertos árboles. El control a este parásito fue la poda de ramas parasitadas (Agrios, 2005).
-
Granjeros notaron la presencia de roya en plantaciones de trigo cercano a arbustos de Berberis y relacionaron la enfermedad a dichos arbustos. En Francia ,se elaboró la Primera Legislación Regulatoria de Enfermedades en Plantas, la cual prohibía la presencia de arbustos de Berberis cerca a trigo (Agrios, 2005).
-
El médico francés Thoullier, observo que el ergotismo o "fuego sagrado" causaba grave enfermedas y a veces la muerte. Se asoció al consumo de granos contaminados con Claviceps purpurea "ergot" (Agrios, 2005).
-
Pier Micheli descubre muchos géneros de hongos y los ilustra con sus estructuras de reproducción. Propone que el crecimiento de hongos se da por esporas propias del hongo espontáneamente (Agrios, 2005).
-
Carlos Von Linne (botánico), publico "Systema Naturae". Su obra establecía el diagnóstico de las especies de plantas y su sistema binomial de nomenclatura (Agrios, 2005).
-
Prevost, descubrió que al rociar semillas con esporas de hongos con sulfato cúprico, la germinación de las semillas se daba mientras que semillas no rociadas con el compuesto se pudrían (Agrios, 2005).
-
Robert Petri, inventó las cajas petri y se simularon las condiciones nutricionales para microorganismo al agregar los primeros medios de cultivo artificiales (Agrios, 2005).
-
Experimentos en planta de Tabaco que dieron como resultado que el agente causal de la enfermedad no era una bacteria sino "un fluido contagioso con vida" al que lo denomino Virus.
-
La ciencia sigue avanzando, aunque se conoce acerca de patógenos en plantas, el campo de estudio sigue siendo sumamente amplio. Existen libros sumamente educativos como el publicado por George Agrios en el 2005.
Want to make a timeline like this?
Use Timetoast to turn dates, events, milestones, and phases into a clear visual timeline you can build and share. Timetoast is a timeline maker for work, school, research, and stories.